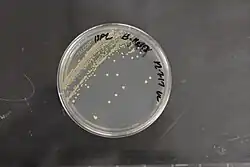

Streptomyces caniferus
| Streptomyces caniferus | |
|---|---|
| |
| Scientific classification | |
| Domain: | Bacteria |
| Kingdom: | Bacillati |
| Phylum: | Actinomycetota |
| Class: | Actinomycetes |
| Order: | Streptomycetales |
| Family: | Streptomycetaceae |
| Genus: | Streptomyces |
| Species: | S. caniferus
|
| Binomial name | |
| Streptomyces caniferus (ex Krassilnikov 1970) Preobrazhenskaya 1986[1]
| |
| Type strain | |
| AS 4.1588, ATCC 43699, BCRC 16851, CCRC 16851, CGMCC 4.1588, DSM 41453, IFO 15389, INMI 377, JCM 6914, NBRC 15389, NRRL B-16358, VKM 68, VKM Ac-68 | |
| Synonyms[2] | |
| |
Streptomyces caniferus is a bacterium species from the genus of Streptomyces.[1][2]
See also
References
- ^ a b "LPSN bacterio.net". Archived from the original on 2015-09-23. Retrieved 2015-11-22.
- ^ a b Deutsche Sammlung von Mikroorganismen und Zellkulturen [1] Archived 2015-11-22 at the Wayback Machine
Further reading
- Garrity, George M. (2012). Bergey's manual of systematic bacteriology (2nd ed.). New York: Springer Science + Business Media. ISBN 978-0-387-68233-4.
External links